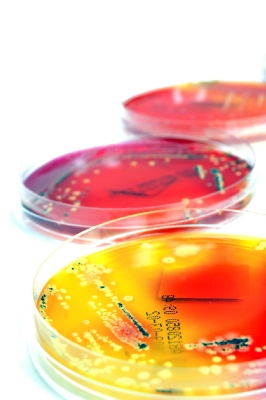

()
Contact Us For Details
Boost Labcare is a UKAS accredited organisation with 25 years experience providing laboratory support. Our service and calibration capabilities cover a large range of laboratory equipment and we also supply a range of new and refurbished laboratory equipment from Autoclaves to Consumables. We are an independent supplier, which means we can source equipment exactly to your requirements, at the best price.